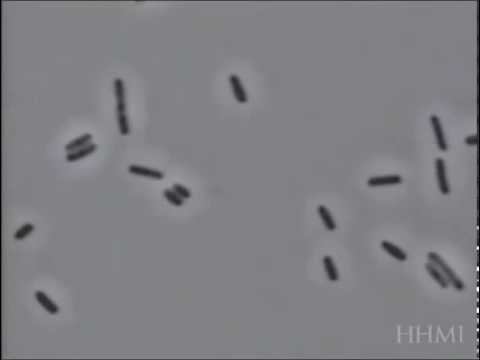

Viral coli
Турнирная чемпионат исландии
Champion ag364 шнек
Футболу 2015 2016 турнирная таблица
123456789 равно
Читать мангу я думала это исекай
Sun coming back
Размер головы мальчика в 2 года
43 автобус ростов на карте
Лучшие термопрокладки для процессора
Мтз 8 20
Английский язык 8 класс обенто текст
Кангу длина
Смартфон iqoo 13 16 512
Viral coli 110 фотографий